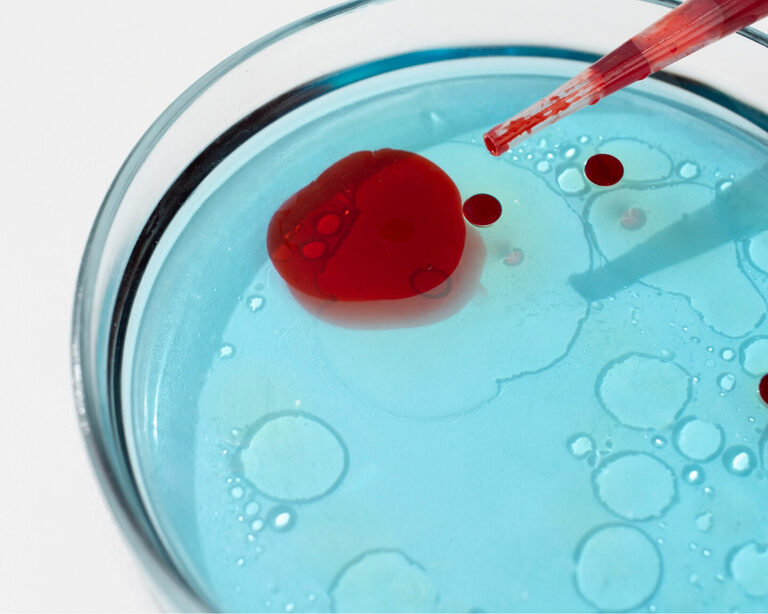
Что такое HbA1c и почему он важен

Согласно данным Всемирной организации здравоохранения (ВОЗ), 800 миллионов человек в мире страдают от диабета, что делает точные инструменты контроля, такие как HbA1c, всё более актуальными. Гликированный гемоглобин, или HbA1c, является показателем, который отражает стабильность уровня сахара в крови за последние два-три месяца.
По сути, когда глюкоза циркулирует в крови, она частично присоединяется к молекулам гемоглобина. Чем выше уровень сахара, тем больше получается «сахарного» гемоглобина. Именно поэтому врачи часто используют HbA1c для диагностики и контроля диабета.
Методы измерения HbA1c
Существует несколько методов измерения HbA1c, каждый из которых имеет свои преимущества и недостатки. Одним из самых распространённых способов является высокоэффективная жидкостная хроматография (ВЭЖХ). Этот метод позволяет очень точно разделять разные формы гемоглобина и выявлять даже небольшие отклонения. Другой популярный метод – иммунотурбидиметрия. Он быстрее и удобнее для автоматизированных лабораторий, но может не учитывать редкие варианты гемоглобина, что иногда даёт небольшие расхождения в результатах.
Также применяют ферментативные и другие колориметрические методы. Эти способы основаны на реакциях, в ходе которых меняется цвет раствора в зависимости от количества HbA1c. Несмотря на то, что они могут быть менее точными, их часто используют в небольших клиниках благодаря простоте выполнения. Важно, что все современные лаборатории стремятся к стандартизации результатов, чтобы измерения были сопоставимыми, независимо от используемого метода.
Значение HbA1c в медицине
HbA1c помогает врачам понять, как долго у пациента сохраняется высокий уровень сахара в крови, что напрямую связано с риском развития осложнений диабета, таких как проблемы с глазами, почками и нервной системой. Исследования показывают, что даже незначительное снижение уровня HbA1c может существенно снизить риск повреждения мелких кровеносных сосудов. Врачи рекомендуют для большинства пациентов держать этот показатель ниже 7%, чтобы защитить организм от долгосрочных осложнений.
Особенности у разных групп
У детей, подростков, взрослых, пожилых людей и беременных женщин интерпретация значения HbA1c может различаться. Например, у детей с диабетом часто ставят цель – поддерживать HbA1c ниже 7%, хотя на практике добиться этого довольно сложно из-за гормональных колебаний и трудностей с соблюдением режима.
У взрослых цель обычно – около 7%, однако индивидуальные особенности, такие как длительность болезни и сопутствующие проблемы, могут требовать более мягких или строгих показателей. Важно понимать, что слишком резкое снижение сахара может привести к частым эпизодам гипогликемии, что особенно опасно для пожилых людей.
Пожилым пациентам часто рекомендуется более высокий показатель – около 7–7,5%, поскольку их организм менее устойчив к резким колебаниям уровня сахара. Важно избегать не только гипергликемии, но и опасных приступов низкого сахара, которые могут привести к падениям и другим последствиям.
Беременные женщины – особая категория. Из-за физиологических изменений у них естественно ниже уровень HbA1c, а строгий контроль помогает снизить риск врожденных дефектов и осложнений у плода. Поэтому у беременных с диабетом цель обычно – около 6–6,5%.
Как HbA1c помогает прогнозировать осложнения
Многочисленные исследования доказали, что уровень HbA1c тесно связан с развитием осложнений диабета. Пациенты, у которых показатель стабильно ниже, реже сталкиваются с проблемами со зрением, почками и нервной системой. Снижение HbA1c на 1% может привести к значительному уменьшению риска повреждения сосудов. Это объясняется тем, что высокий уровень сахара вызывает повреждение мелких сосудов. Два человека с одинаковым уровнем HbA1c могут иметь различные схемы колебаний уровня сахара в крови. Поэтому современные исследования уделяют внимание не только среднему значению, но и вариативности глюкозы, используя системы непрерывного мониторинга. Такие показатели, как «время в целевом диапазоне», помогают врачам получить более полную картину и лучше подобрать лечение.

Будущие перспективы исследований
Исследования продолжаются, и учёные не останавливаются на достигнутом. Искусственный интеллект уже тестируется для анализа данных HbA1c и прогнозирования осложнений с учётом индивидуальных факторов. Активно изучают возможность использования дополнительных биомаркеров, таких как фруктозамин и гликированный альбумин, которые отражают уровень сахара за более короткий период. Это особенно важно в случаях, когда традиционный HbA1c может быть искажен (например, при анемии или изменённом обмене эритроцитов).
Ведутся исследования по индивидуальным особенностям гликирования. Возможно, в будущем врачи будут учитывать не только HbA1c, но и генетические факторы, что позволит лучше подбирать индивидуальное лечение для каждого пациента. HbA1c остаётся основой контроля диабета. С развитием технологий и персонализированной медицины его роль может расшириться, помогая миллионам пациентов избежать тяжёлых последствий.

Кардиология
Инфектология
Онкология
Фертильность
Нефрология
Эндокринология